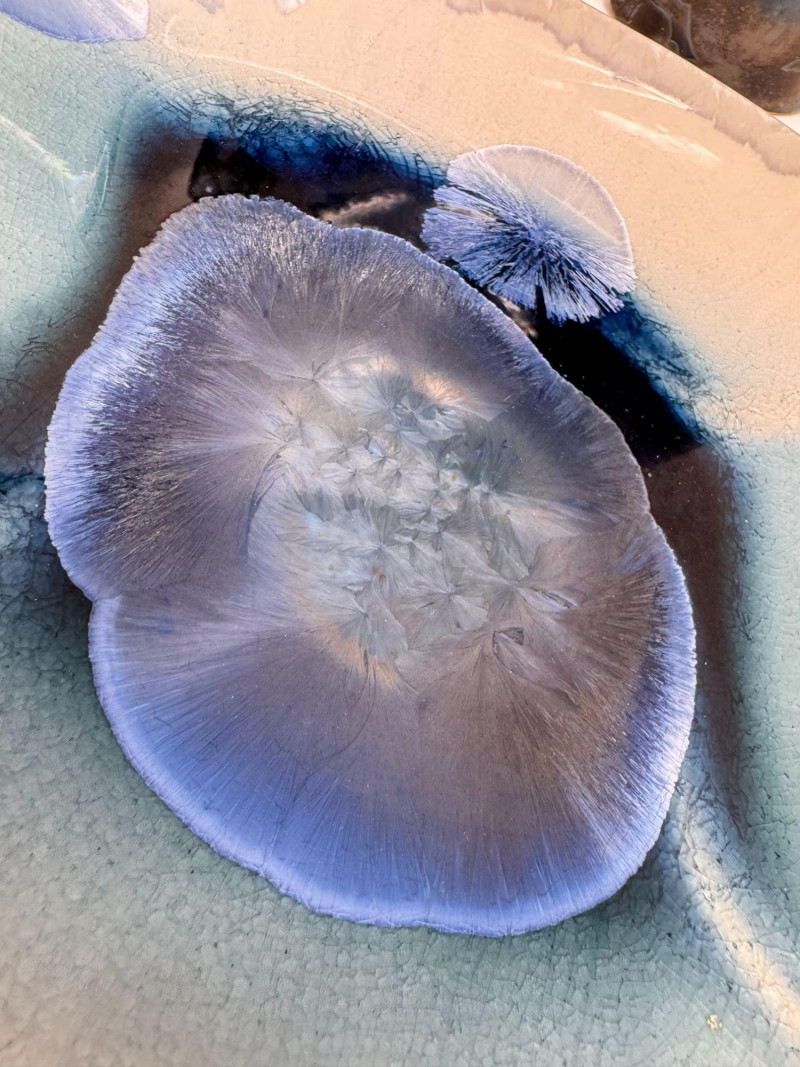

Lot # 9 - Unique Studio Pottery Trio - Vase, Plate, & Wall Bud Vase - Signed
| Opening Bid : | $ 5.00 |
| Start Date/Time: | 29-Apr-2026 7:00:00 AM |
| End Date/Time: | 06-May-2026 7:08:00 PM |
| Current bid: |
$37.00 |
| Highest bidder: | NCK26 |
Auction has ended |
|
Description :
Unique Studio Pottery Trio - Vase, Plate, & Wall Bud Vase - Signed.
Auction History
Highest bidder is NCK26
| Date | Bid | User |
|---|---|---|
| 06-May-2026 5:09:42 PM | $37.00 | NCK26 |
| 01-May-2026 6:50:56 PM | $36.00 | pghanson |
| 01-May-2026 6:50:52 PM | $34.00 | Mbbbchill |
| 01-May-2026 6:50:52 PM | $33.00 | pghanson |
| 01-May-2026 6:25:12 PM | $32.00 | Mbbbchill |
| 01-May-2026 11:47:14 AM | $31.00 | pghanson |
| 01-May-2026 11:21:15 AM | $26.00 | Mbbbchill |
| 01-May-2026 11:21:10 AM | $25.00 | pghanson |
| 01-May-2026 11:21:10 AM | $25.00 | Mbbbchill |
| 01-May-2026 11:18:33 AM | $21.00 | pghanson |
| 01-May-2026 11:18:33 AM | $20.00 | Mbbbchill |
| 29-Apr-2026 11:17:00 AM | $16.00 | pghanson |
| 29-Apr-2026 11:16:55 AM | $15.00 | 2156 |
| 29-Apr-2026 11:16:55 AM | $15.00 | pghanson |
| 29-Apr-2026 7:51:54 AM | $5.00 | 2156 |
PAYMENT DETAILS
Placing a bid is an agreement to purchase. If you win, you must pick up your item(s). If you default on your purchase, your bidding privileges will be revoked permanently. Do not bid if you do not plan to purchase.If you bid, you MUST be available/arrange for pick-up of purchases on the pick-up date unless you have made prior shipping arrangements. Bring necessary tools and help for picking up large items. Loading assistance is NOT available. Some items may be located on a 2nd floor, out building.
Invoices are emailed to winning bidders once the sale has completely closed.Full payment must be made by 8:00 p.m. the day after auction closes. If total payment is not received before the pick-up date & time, items will be forfeited, and bidding privileges revoked.
Pick-up information will be on the invoice e-mailed after the auction closes.All items not picked up during the designated times will be considered abandoned and may be donated or resold. When possible, and at our sole discretion, an alternate pick-up time may be arranged. If this is possible, an appropriate fee will be charged.
A Buyer's Premium and Sales Tax are added to the winning bid amount when invoiced. Sales tax is waived for licensed re-sellers.
We make every effort to describe lot items as accurately as possible. Expect normal signs of wear associated with antiques, vintage, and used items. We do not list every flaw. All items are sold AS IS WHERE IS. No refunds or returns. East Side Estate Liquidation Company does not guarantee the working order of any clock, watch, electronic or mechanical device. Dimensions given may be approximate.
 menu
menu